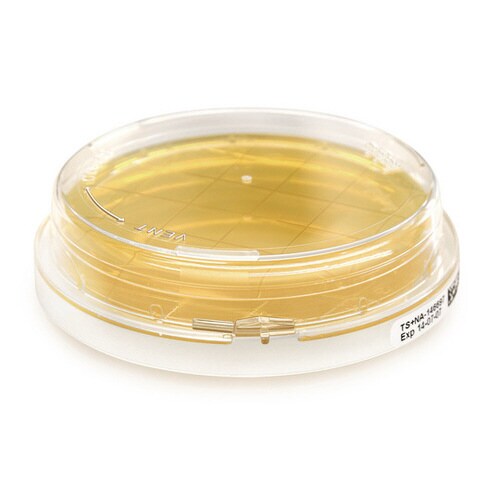
ICRプラスコンタクトプレート (含有成

入数 1箱(20枚) 販売価格 ¥9,216 (税込)
Merck
ICRプラスコンタクトプレート (含有成分:レシチン、ポリソルベート80)1箱(20枚入) 1.46552.0020
【3127-0311】



| ¥9,216 (税込) / ¥8,379 (税抜) |
| ¥9,216 (税込) / ¥8,379 (税抜) |
| メーカー希望小売価格※税抜 (割引率) ¥8,820(5%) |
|---|
培地関連用品の売れ筋ランキング
- ¥9,927(税込) (税込) 〜
- ¥11,547(税込) (税込) 〜
- ¥8,162(税込) (税込) 〜
- ¥6,030(税込) (税込)
商品の特徴 |
三重包装になっており、アイソレーターやクリーンルームの環境測定培地として使用可能です。フタを回すことで容易にロックできますので、落としてもはずれず二次汚染が防げます。 |
|---|---|
商品仕様 |
|
メーカー情報 |
|
カタログ掲載ページ |
-/- |
| 注意事項 | ※【返品に関するご注意】この商品は直送品のため、お客様のご都合による返品はお受けできません。 |
|---|